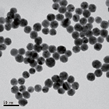
Gold-Citric Acid Colloid 30nm

Gold Colloids

TANAKA offers high-quality products with prompt and thorough support.
By our own proprietary synthesis processes, we supply qualified gold nano particles for rapid diagnostics and biosensors, which we supply using a high quality management system.
Gold-Citric Acid Colloidal Solution
Features
- Colloid solution in which nanosized gold particles are dispersed
- Spherical gold particles with high-purity and a narrow particle size distribution
- Easy to modify gold particle surfaces
- Colloids can be supplied in the quantity and in the time required as they are manufactured in Japan
- Colloids can be supplied at a stable level of quality with little variation between lots

15nm
30nm

40nm

50nm

80nm

100nm
Applications
Gold-citric acid colloidal solution is used in in-vitro diagnostic and other test kits.
It is ideal for use in test reagents, biomarkers, X-ray identification markers, etc.
Typical characteristics
| Particle size (nm) |
Solvent | Color | Shape | Particle size range | Gold content (Wt%) |
pH |
|---|---|---|---|---|---|---|
| 5 | Water | Light orange – Dark red |
Spherical shape |
10% or less in relation to particle size |
0.004~0.005 | 4.5 |
| 15 | 0.006~0.007 | 5.5 | ||||
| 20 | 5 | |||||
| 30 | 4 | |||||
| 40 | 3.5 | |||||
| 50 | 3 | |||||
| 60 | 3 | |||||
| 80 | 3 | |||||
| 100 | 3 | |||||
| 150 | 3 |
![[Absorbance comparison graph] 5nmΦ~100nmΦ](jpg/img_block02_01-21.jpg)
Absorbance
![[Au particle size comparison graph] 5nmΦ~100nmΦ](jpg/img_block02_02-17.jpg)
Au particle size
